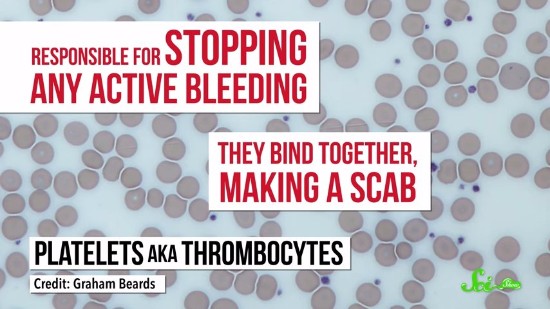

2018.01.10
「定価」があるのは日本だけ? 輸入ビジネスアドバイザーが説く、日本の商習慣の問題点

2018.01.09
輸入ビジネスに英語力はいらない!? たった3ワードで乗り切れる、海外企業との交渉のコツ

2018.01.09
古代の堆積物から推測する未来の地球の姿

2018.01.08
1年の3分の1は海外に 「輸入ビジネスアドバイザー」の仕事とは?
2018.01.08
薬を服用していると献血できないことがあるのはなぜ?

2018.01.07
雪だるま=snowman では「雪男」は英語でどう言う?

2018.01.07
飲酒で体内は消毒されるのか?

2018.01.06
アナ雪の『Let It Go』の歌詞は日本語と英語でぜんぜん違う! 大ヒット作に隠された意外な真実

2018.01.06
地下資源の採掘や廃水の放出が地震の要因になっている?

2018.01.05
アナ雪の「生まれてはじめて」の原題は『For The First Time In ◯◯』 映画で学ぶ英語表現

2026.06.19
できる人が「まめに上司に確認」していること 自分にばかり意識が向いている人は成長しづらい

2026.06.12
管理職に向いているのは「有能な怠け者」 組織に「無能な働き者」が悪影響をもたらすわけ

2026.06.15
管理職の空回りを減らす4象限の解決アプローチ 「がんばるだけ損」と社員が感じる本当の理由

2026.06.18
がんばっているのに成果が出ない人の共通点 間違った努力をやめて消耗せずに成功するヒント

2026.06.16
部下が動きやすい“指示の型”の作り方 優れたフレームワークが持つ3つの条件

2026.06.22
40歳までに年収1,000万円を超えるためにすべきこと 20代で選ぶべき「環境」と「行動」

2026.06.17
部下への“ふわっと指示”を脱するフレームワークのコツ 認識のズレないコミュニケーションを生む4つのステップ

2014.07.03
【書き起こし】野々村竜太郎県議、"号泣"記者会見 「キッチリ報告してんのに、なんで自分を曲げんといかんのや」

2015.11.24
人は食事をしないとどうなるか 餓死に至る3つのステップ

2026.06.08
1on1がうまい上司は部下の愚痴を“翻訳”できる 現場の不満から組織課題を改善する思考法